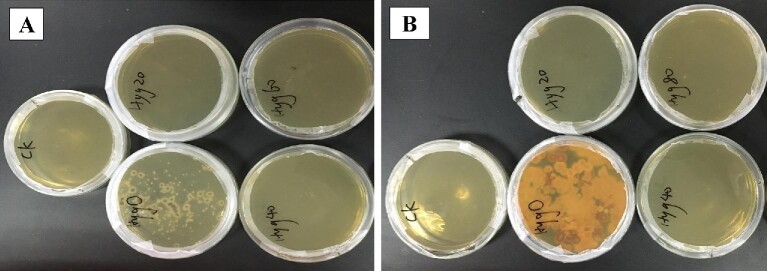
Fig. 1.

Genetic evidence for the requirements of antroquinonol biosynthesis by Antrodia camphorata during liquid-state fermentation
Abstract
The solid-state fermentation of Antrodia camphorata could produce a variety of ubiquinone compounds, such as antroquinonol (AQ). However, AQ is hardly synthesized during liquid-state fermentation (LSF). To investigates the mechanism of AQ synthesis, three precursors (ubiquinone 0 UQ0, farnesol and farnesyl diphosphate FPP) were added in LSF. The results showed that UQ0 successfully induced AQ production; however, farnesol and FPP could not induce AQ synthesis. The precursor that restricts the synthesis of AQ is the quinone ring, not the isoprene side chain. Then, the Agrobacterium-mediated transformation system of A. camphorata was established and the genes for quinone ring modification (coq2-6) and isoprene synthesis (HMGR, fps) were overexpressed. The results showed that overexpression of genes for isoprene side chain synthesis could not increase the yield of AQ, but overexpression of coq2 and coq5 could significantly increase AQ production. This is consistent with the results of the experiment of precursors. It indicated that the A. camphorata lack the ability to modify the quinone ring of AQ during LSF. Of the modification steps, prenylation of UQ0 is the key step of AQ biosynthesis. The result will help us to understand the genetic evidence for the requirements of AQ biosynthesis in A. camphorata.
Figures
Fig. 1.
Effect of different concentrations of…
Fig. 1.
Effect of different concentrations of hygromycin B on the growth of A. camphorata…
Fig. 1. Effect of different concentrations of hygromycin B on the growth of A. camphorata S-29. A: The cell age of A. camphorata S-29 was 8 days; B: The cell age of A. camphorata S-29 was 31 days. Cells growth at 20, 40, 60 and 80 mg/L hygromycin B and the plate without antibiotic was set as a control.
Fig. 2.
Agrobacterium-mediated transformation system of the…
Fig. 2.
Agrobacterium-mediated transformation system of the A. camphorata S-29. A: Selection of A. tumefaciens…
Fig. 2. Agrobacterium-mediated transformation system of the A. camphorata S-29. A: Selection of A. tumefaciens; B: A. camphorata S-29 cell age; C: A. camphorata S-29 biomass; D: Co-culture time of A. tumefacien LBA4404 and A. camphorata S-29; E: Co-culture temperature; F: A. tumefacien LBA4404 concentration; G: Acetosyringone concentration; H: Oscillation duration; I: PCR detection of hyg gene in the transformants of A. camphorata S-29 (wt: wild-type; M: Maker of DL2000; 1-6: Transformants of A. camphorata S-29). Results are express as the mean ± SEM for each experimental group (n = 3). The significance of differences between the data was assessed using One-way ANOVA by Dunnett's tests, with the level of significance set at p < 0.05.
Fig. 3.
Evaluation the role of exogenous…
Fig. 3.
Evaluation the role of exogenous addition precursors on AQ biosynthesis. A: Chromatogram of…
Fig. 3. Evaluation the role of exogenous addition precursors on AQ biosynthesis. A: Chromatogram of A. camphorata in SSF; B: Chromatogram of A. camphorata in LSF; C: AQ was a structural analog of UQ3; D: Chromatogram of A. camphorata in LSF with addition of UQ0; E: Chromatogram of A. camphorata in LSF with addition of farnesol; F: Chromatogram of A. camphorata in LSF with addition of FPP; G: Chromatogram of A. camphorata in LSF with addition of UQ0 and farnesol; H: Chromatogram of A. camphorata in LSF with addition of UQ0 and FPP; I: Yield of AQ and Ac in different groups.
Fig. 4.
Construction of the recombinant plasmid…
Fig. 4.
Construction of the recombinant plasmid based on pCAMBIA 1301. A: A. camphorata S-29…
Fig. 4. Construction of the recombinant plasmid based on pCAMBIA 1301. A: A. camphorata S-29 and the target gene (coq2, coq3, coq5, coq6, fps, HMGR); B: Construction of plasmids based on pCAMBIA 1301 and verified in A. tumefaciens LBA4404. M, M1 and M2 = markers of DNA with different molecular weight. Target gene: q2 = coq2, q3 = coq3, q5 = coq5, q6 = coq6, HMGR = HMG-CoA reductase, fps = FPP synthase. wt = wild-type.
Fig. 5.
Transformation of A. camphorata S-29.…
Fig. 5.
Transformation of A. camphorata S-29. A: Agrobacterium -mediated transformants and detection of hyg…
Fig. 5. Transformation of A. camphorata S-29. A: Agrobacterium-mediated transformants and detection of hyg gene in transformants of A. camphorata S-29. B: Growth of transformants of A. camphorata S-29 in PDA plate with hygromycin B. M = marker of DNA. wt = wild-type.
Fig. 6.
Effect of overexpression of quinone…
Fig. 6.
Effect of overexpression of quinone ring modification genes from A. camphorata S-29 on…
Fig. 6. Effect of overexpression of quinone ring modification genes from A. camphorata S-29 on AQ biosynthesis. A: Yield of AQ and Ac in different transformants. B: The colony morphology and chromatogram of transformant with pCAMBIA1301. C: The colony morphology and chromatogram of transformant with pCAMBIA1301-coq2. D: The colony morphology and chromatogram of transformant with pCAMBIA1301-coq3. E: The colony morphology and chromatogram of transformant with pCAMBIA1301-coq5. F: The colony morphology and chromatogram of transformant with pCAMBIA1301-coq6.
Fig. 7.
Effect of overexpression of side…
Fig. 7.
Effect of overexpression of side chain genes from A. camphorata S-29 on AQ…
Fig. 7. Effect of overexpression of side chain genes from A. camphorata S-29 on AQ biosynthesis. A: Yield of AQ and Ac in different transformants. B: The colony morphology and chromatogram of transformant with pCAMBIA1301. C: The colony morphology and chromatogram of transformant with pCAMBIA1301-fps. D: The colony morphology and chromatogram of transformant with pCAMBIA1301-HMGR.
Fig. 8.
The global pathway of AQ…
Fig. 8.
The global pathway of AQ synthesis in A. camphorata . As a precursor,…
Fig. 8. The global pathway of AQ synthesis in A. camphorata. As a precursor, UQ0 could significantly reduce the synthesis steps of AQ. All figures (8)